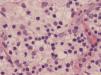
fig0015

Niña de 3 años de edad, de origen nigeriano, que presenta linfadenopatías cervicales gigantes de un año de evolución (fig. 1). El cuadro clínico ha cursado de forma insidiosa con crecimiento progresivo, periodos de estabilización y mejoría parcial. Las pruebas de imagen localizaban la enfermedad a la región cervical. Los estudios para micobacterias, anaerobios, hongos, toxoplasma, Bartonella y virus fueron repetidamente negativos. El diagnóstico anatomopatológico mediante biopsia ganglionar reveló un patrón de histiocitosis sinusal con emperipolesis característico de la enfermedad de Rosai-Dorfman (figs. 2 y 3).
ComentarioLa enfermedad de Rosai-Dorfman es una enfermedad proliferativa benigna, poco frecuente, ocasionalmente confundida con procesos malignos como linfomas u otros tumores dependiendo de su localización y poco diagnosticada en la edad pediátrica1. Su manifestación más frecuente es la presencia de adenopatías gigantes a nivel cervical, axilar o inguinal, de consistencia dura y generalmente múltiples. Se caracteriza por su curso larvado, indolente y benigno cuya única manifestación clínica puede ser la febrícula o pérdida de peso. Sin embargo, hasta en un 43% de los casos puede existir afectación extranodal implicando regiones como mediastino sistema nervioso central, cavidad nasal, glándulas salivares, pulmón o hueso2,3 y existiendo, en ocasiones, complicaciones severas generalmente por efecto masa. Es necesario un seguimiento a largo plazo dado el riesgo de complicaciones y recaídas. Pese a que es frecuente la resolución espontanea, el tratamiento continúa siendo controvertido sobre todo en casos severos. Se han descrito tratamientos con corticoides, metotrexate, 6-mercaptopurina o resección quirúrgica con eficacia variable4.